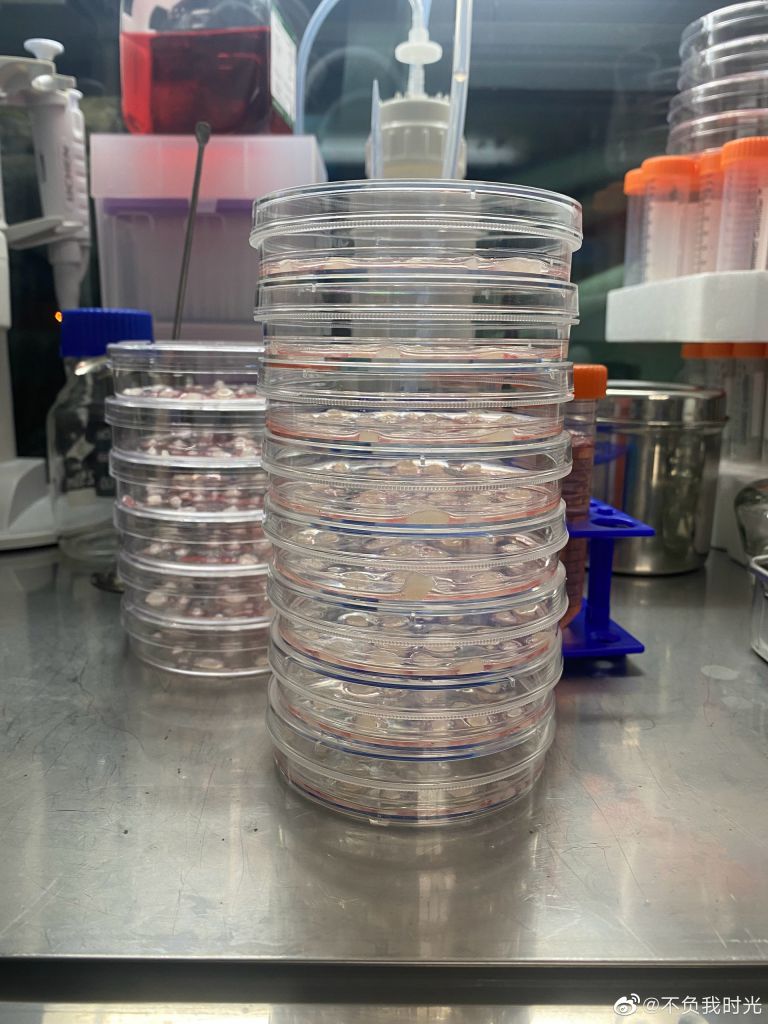
無論是製藥環境、原料抑或製劑都通過檢測。

雲南童患遺傳病 父親自製藥救子:很多患兒在等死,望幫助更多人
- [香港01]雲南兩歲三個月大男童徐灝洋,去年確診患上遺傳性銅缺乏疾病Menkes綜合症(Menkes syndrome),為了緩解症狀,他每晚睡前都要注射「組氨酸銅」。 由於新冠肺炎疫情斷了境外就醫拿藥的渠道,國內藥廠亦需要幾年才可將藥物上市,只有高中學歷的徐偉決定為兒子自製藥物。 徐偉製藥救子觸動人心,卻又牽涉到藥物安全及法律問題。然而,徐偉不僅是為了兒子,更希望能為患兒出一分力,「很多孩子都在等死,(自己)想能幫助更多的人」。......
雲南兩歲三個月大男童徐灝洋,去年確診患上遺傳性銅缺乏疾病Menkes綜合症(Menkes syndrome),為了緩解症狀,他每晚睡前都要注射「組氨酸銅」。
由於新冠肺炎疫情斷了境外就醫拿藥的渠道,國內藥廠亦需要幾年才可將藥物上市,只有高中學歷的徐偉決定為兒子自製藥物。
徐偉製藥救子觸動人心,卻又牽涉到藥物安全及法律問題。然而,徐偉不僅是為了兒子,更希望能為患兒出一分力,「很多孩子都在等死,(自己)想能幫助更多的人」。
據介紹,Menkes 綜合症是一種遺傳性的罕見病,人體由於X染色體上的ATP7A基因發生變異,導致身體無法吸收銅離子,大多見於男童。患兒無法正常發育,還會出現退行性神經病變,在不斷的感染直到體內某個器官率先衰竭,最終離世。
《新浪科技》報道,徐偉坦言,兒子在日常生活中根本離開不人,「他不能抬頭,無力吞嚥,身體也非常軟,並且有很多的併發症」。他表示,全國醫院都沒有組氨酸銅,所以也沒有治療方案。在確定國內沒有辦法買到藥,藥廠也不可能幫忙製備的情況下,就決定要自己製藥。
在製藥前,徐偉花費一個半月搜查大量資料,「不懂的就查,有時間就查,只要一閒下來就開始查,一點一滴地積累」。他曾租用上海共享實驗室製藥,是他第一次也是唯一一次在外製藥,對於是否有擔心過安全問題,徐偉表示,最困難的是如何理解知識,自己只能通過不停查詢文獻,來確保製備化合物的安全性。
對於罕見的基因病,目前最根本的治療方案是基因療法。對於國內的基因療法水平,徐偉指出,基因疾病特別多,大部分人肯定會先關注患者較多的疾病,所以基因療法是一個慢慢發展的狀態,他更希望通過自己的故事助推基因藥物的研發加快。
「因為畢竟每一種基因病背後都是無數條人命」
據了解,灝洋每晚睡前都要注射藥物以緩解症狀。對於兒子用藥及製藥的頻率,徐偉介紹,灝洋每天都要注射組氨酸銅,至於另一種藥「伊利司莫銅」曾用了3個月,但因為要靜脈注射,「現在停了,先讓血管恢復一下」。目前,組氨酸銅一個月會製備一次,伊利司莫銅則因為停用不需製備。
目前,徐偉正研發幹細胞實驗和基因編輯器。他介紹,已成功培養出幹細胞,但仍需要做完相關的檢測,確保安全性後才給兒子,「幹細胞能夠起到一個什麼樣的作用,對於這個病來說還不確定,但是通過它的機理,應該可以去極大地改善孩子的併發症,提高他的免疫力,重塑他的血管」。
徐偉為子自製藥的事引起輿論,但他坦言,當初接受傳媒採訪是覺得自製藥已到達瓶頸,而僅靠自己研究基因治療,資金不足及進度慢是主要問題。雖然他知道自製藥一事是博人眼球,也很少人會選擇自製藥物,「但為了孩子,只要他能有多一份的希望,我就豁出去了」。
徐偉製藥惹外界關注,但亦引起不少法律層面的討論,比如藥物監管和行醫資格的問題。徐偉表示,從未將自己當成一個行醫者,他只在病友群組中分享知識,所以算是在病友群組內的交流。至於製藥方面,任何藥物都必須要經過國家審核才能成為藥,因此你認為自己製備的是化合物,「剛好這個化合物對我的孩子的病是有幫助的」。
國家衛健委曾表示,只要徐偉不售賣就不存在危害社會,同時有關部門就不會干涉。然而,不少患兒極需要用藥。徐偉指出,自己想為病友出一分力,希望通過媒體報道獲得幫助,不管是從法律層面上或者是有關部門方面,能否盡量避免這種尷尬的局面,「很多孩子都在等死,然後沒有藥用,剛好我也可以製備出來,國家也沒有別的藥企願意去製備,但是因為法律法規的問題,怎麼樣能夠打破這種僵局,因為本身我是抱着一顆初心,想能幫助更多的人」。
資料來源: 香港01
網址: 原文網址
作者: 林芷瑩
 罕見疾病,雲南,自製藥物
罕見疾病,雲南,自製藥物
Previous 26周早產嬰僅手掌般大 奮鬥2個月終健康出院與家人團聚 Next 日本好媽媽保護幼女致燒傷毀容斷指 克服傷殘養大3兒女感動全國